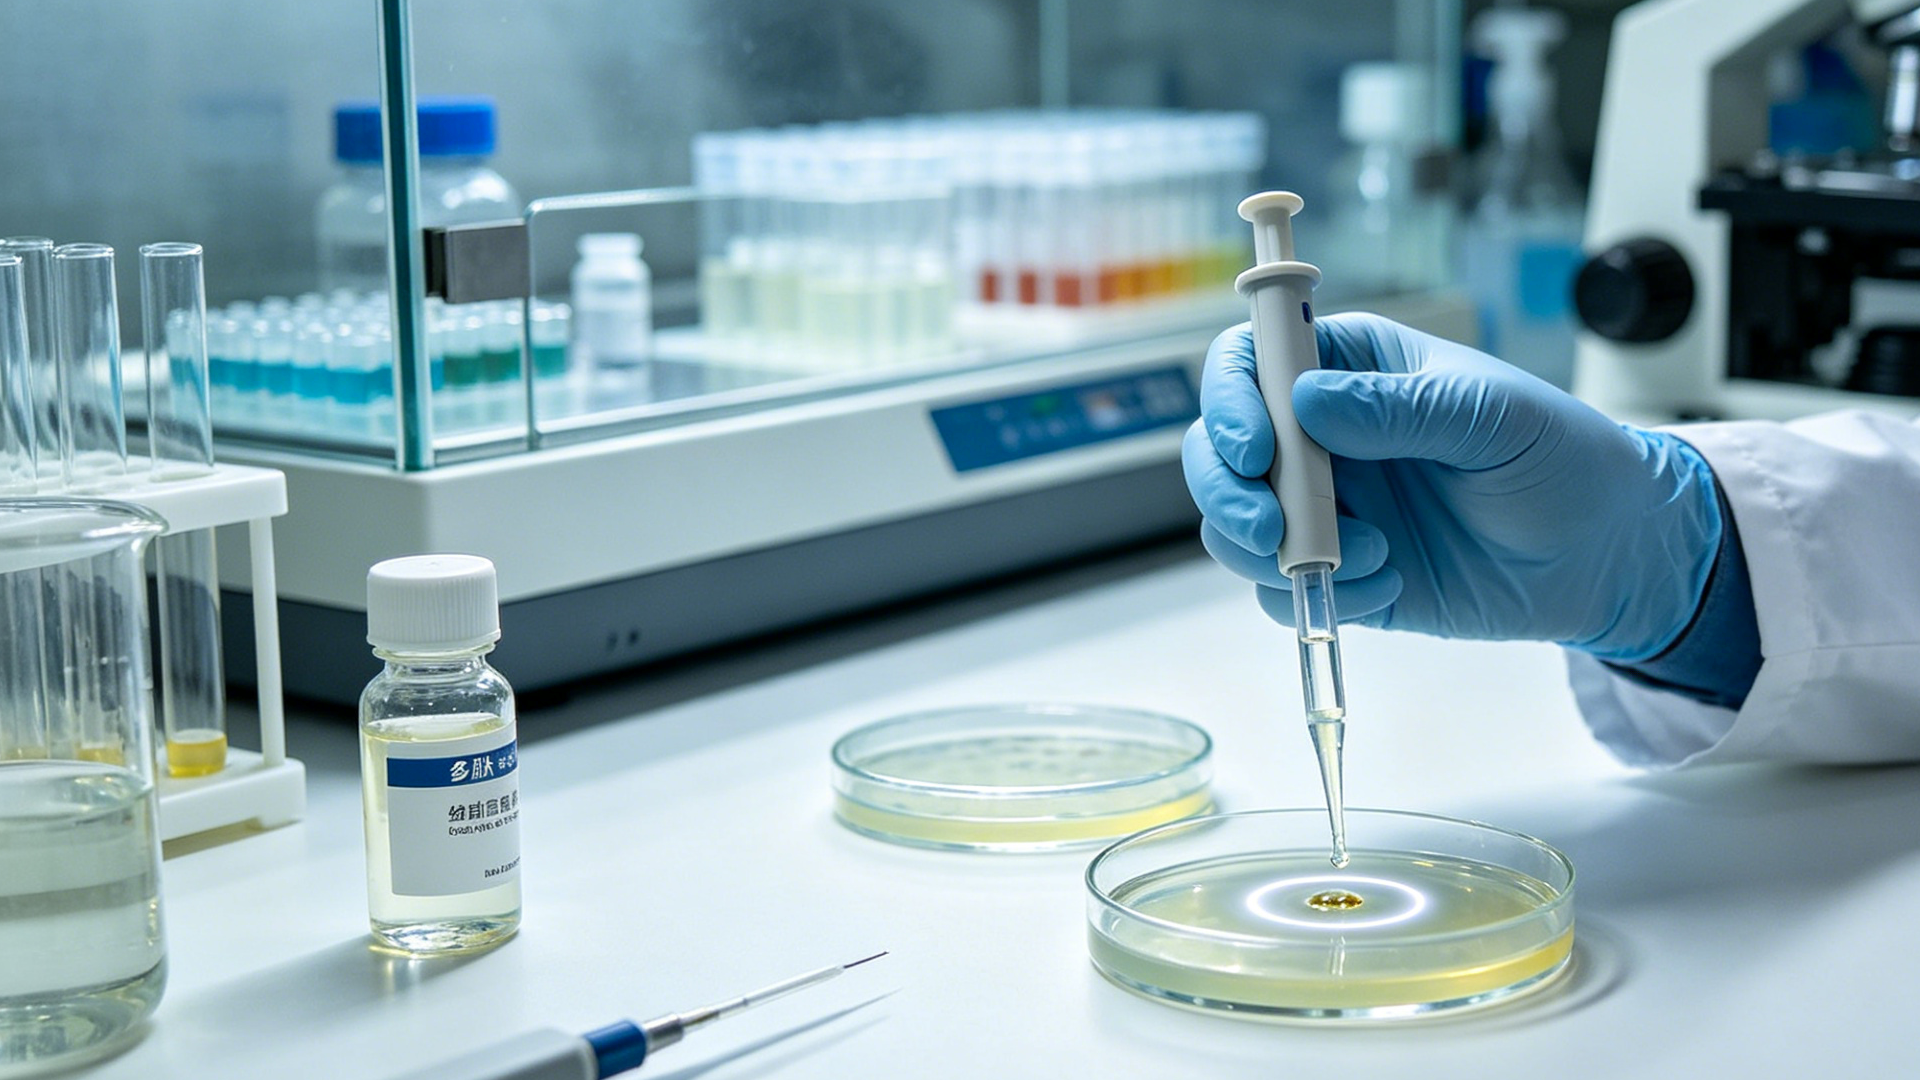

Aangepaste peptide synthese is een hoeksteen geworden van de moderne wetenschap. Van levensreddende geneesmiddelen tot hoogwaardige beautyproducten, deze gespecialiseerde moleculen zijn overal. Omdat peptiden natuurlijke biologische processen kunnen nabootsen, bieden ze ongeëvenaarde precisie in veel velden. Hieronder verkennen we de belangrijkste toepassingen van aangepaste peptiden in de huidige wereldmarkt.
Een van de meest kritieke toepassingen van aangepaste peptiden is in de vaccinontwikkeling. Door specifieke antigeenpeptiden te synthetiseren, kunnen onderzoekers het immuunsysteem misleiden om virussen zoals HIV of griep te herkennen en te bestrijden. Bovendien zijn peptiden een game-changer in de kankerimmunotherapie. Wetenschappers creëren aangepaste peptiden die T-cellen helpen om tumorcellen te identificeren en te vernietigen, waardoor een gerichte manier om kanker te behandelen met minder bijwerkingen dan traditionele chemo wordt geboden.
In de wereld van de farmacologie is gerichte geneesmiddelontwikkeling een topprioriteit. Peptiden zijn perfect hiertoe, omdat ze kunnen worden ontworpen om alleen aan specifieke receptoren of enzymen te binden. Hierdoor kunnen artsen geneesmiddelen precies waar ze nodig zijn afleveren. Daarnaast zijn peptiden essentieel in de moleculaire diagnostiek. Ze fungeren als zeer gevoelige sondes in tests zoals ELISA om ziektebiomarkeurs te detecteren, wat bijdraagt aan vroege diagnose en betere patiëntresultaten.
Onderzoekers gebruiken aangepaste peptiden om de mysteries van de hersenen te ontrafelen. In neurowetenschappelijk onderzoek helpen gespecialiseerde peptiden bij het bestuderen van het werk van neurotransmitters en de ontwikkeling van ziekten zoals Alzheimer. Bovendien zijn peptiden van vitaal belang voor onderzoek naar eiwit-eiwitinteracties. Door delen van een eiwit na te bootsen, laten deze aangepaste ketens wetenschappers zien hoe moleculen met elkaar "praten", wat leidt tot de ontdekking van nieuwe geneesmiddeldoelen.
Naarmate bacteriën resistenter worden tegen oude geneesmiddelen, wordt onderzoek naar antimicrobiële peptiden belangrijker. Aangepaste peptiden kunnen natuurlijke afweermechanismen nabootsen om bacteriën en virussen op nieuwe manieren te doden. Ook in onderzoek naar celsignalisatie worden peptiden gebruikt om specifieke routes te blokkeren of te activeren. Dit helpt onderzoekers om te begrijpen hoe cellen groeien, delen en reageren op hun omgeving, wat sleutel is voor het vinden van nieuwe behandelingen voor chronische ziekten.
Beyond medicine, peptides are transforming the schoonheids- en huidverzorgingsindustrie. Merken gebruiken aangepaste peptiden om producten te creëren die het gedrag van de huid daadwerkelijk veranderen. Bijvoorbeeld kunnen specifieke sequenties collageenproductie stimuleren of diepe hydratatie bieden. Deze wetenschappelijke benadering van schoonheid stelt bedrijven in staat om producten van "med-spa"-kwaliteit te lanceren die zichtbare resultaten leveren aan consumenten.
Bij JIMEIJIAER brengen we de kracht van farmaceutische-grade peptide synthese naar je toiletspiegel. Als merk onder de GL Group gebruiken we wereldklasse onderzoek om hoge-potentie huidverzorging te ontwikkelen. Onze producten, zoals de Multi-Peptide Anti-Rimpel Essentie, zijn ontworpen met dezelfde strenge normen die in medische laboratoria worden gevonden. Door JIMEIJIAER te kiezen, kies je een merk dat de wetenschap van de huid echt begrijpt.
Kortom, de toepassingen van aangepaste peptide synthese zijn bijna eindeloos. Of je nu een nieuw vaccin ontwikkelt, op zoek bent naar een geneesmiddeldoel of een revolutionaire huidverzorgingslijn bij JIMEIJIAER lanceert, peptiden bieden de precisie die je nodig hebt. Naarmate de technologie vooruitgaat, zullen deze kleine maar machtige moleculen blijven leiden op het gebied van gezondheid en schoonheid.
Heb je behoefte aan hoogzuivere peptiden voor je volgende project? Neem vandaag contact op met ons expertteam om te zien hoe we je doelen kunnen ondersteunen!
Copyright © 2026 上海吉尔多肽有限公司 Ltd. All Rights Reserved. POWERED BY WEIMOBTRADE